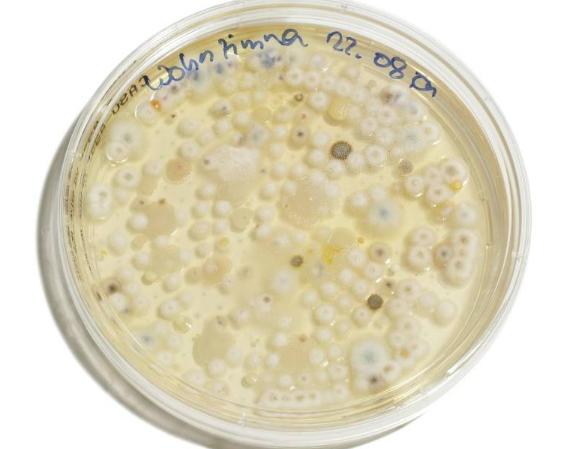

女子吃凉皮后米酵菌酸中毒住进ICU 米酵菌酸毒性激烈无色无味1毫克即可丧命近来,河南省郑州市一名女子在路边摊上吃了一碗凉皮。回家大约两个小时后,她开端厌恶吐逆。这是一种显着的凝血功能障碍和肝功能衰竭,然后她的主意欠好。她大喊大叫,像喝醉了相同,被转到郑州大学隶属第二医院,住进了ICU。经医师查看,该女子被确诊为米酵菌酸中毒。
医师提示,如米皮、冷皮、东北人吃酸汤、长期浸泡真菌、银耳等食物,一旦感觉粘,不要再吃,标明现已恶化。
米酵菌酸,很多人听起来有点生疏,但米酵菌酸毒素食物中毒事件早已发生。女子吃凉皮后米酵菌酸中毒住进ICU 米酵菌酸毒性激烈无色无味1毫克即可丧命
米酵菌酸毒素引起的急性中毒,潜伏期一般为30分钟至12小时,体现为上腹部不适、厌恶、吐逆、腹泻、头晕、全身无力。严峻者有黄疸、吐血、血尿、少尿、认识不清、焦虑、抽搐、抽搐、休克乃至逝世。惋惜的是,现在还没有特效解毒药。一旦中毒,逝世率高达40%。
2020年10月,黑龙江省鸡东县一家9口因食用克己“酸汤”而中毒,最终9人悉数逝世。元凶巨恶是米酵菌酸毒素。
2020年7月28日,广东省揭阳市惠来区域也发生了食用河粉引起的食物中毒事件,11人中毒,1人逝世,也是米酵菌酸毒素。
2010年至2020年10月,全国发生14起中毒,84人中毒,37人逝世。女子吃凉皮后米酵菌酸中毒住进ICU 米酵菌酸毒性激烈无色无味1毫克即可丧命

据报道,“米酵菌酸”是由发酵谷物、椰子和食用菌污染发生的,毒性强,无色无味,高温安稳,首要影响肝脏、大脑、肾脏等重要器官,只要1毫克丧命。
在酷热湿润的气候里,冷皮、河粉、米粉、肠粉等湿米粉,以及浸泡过的银耳、真菌等食物,都简单被椰子毒假单胞菌污染,导致米酵菌酸毒素的发生。椰子毒假单胞菌在自然界中很常见,食用被米酵菌酸污染的食物很简单引起食物中毒。
1.谷物发酵产品,如发酵玉米粉、汽巴、醋冷粉等。散称泡沫米粉(线)类别应挑选外观完好、无发霉、无异味的产品。2.甘薯产品,如马铃薯粉、甘薯面、芋头淀粉等。尽量放在通风防潮的当地,粉末尽量在当天食用,不能彻底密封保存。3.真菌和银耳。试着用温水浸泡,若需求长期浸泡,主张放在冰箱里,但别超越24小时。假如耳朵粘软,气味,有必要丢掉。女子吃凉皮后米酵菌酸中毒住进ICU 米酵菌酸毒性激烈无色无味1毫克即可丧命
1.不要运用发霉的玉米和其他质料。制备发酵面食物时,应常常换水,坚持卫生,保证食物无异味,一经发现粉红色、绿色、黄绿色、黑色等霉点,就不能食用。磨浆后及时枯燥或枯燥成粉末,贮存通风、防潮、防尘。

2.禁止出售或食用蜕变银耳,不得自行食用新鲜银耳。正常干银耳浸泡后,细菌片呈白色或微黄色,形状完好,耐性好,无异味,银耳彻底冲刷,去除基底,浸泡后及时食用,冷拌前用热水烫。
3.购买马铃薯粉丝等食物时,要注意生产日期,保证新鲜;购买外观不发霉、外观规整、色彩正常的产品;购买后应保存在阴凉、通风枯燥的当地;一经发现酸败或发霉,立马中止食用。
省商场监督局指出,中毒后,客户应立马中止食用反常食物,并及时就医。中毒患者应及时吐逆、洗胃、清肠,并依据病况的严峻程度给予症状医治
声明:本站原创/投稿文章一切权归都市时髦一切,转载必须标示清晰来历;文章仅代表原作者观念,不代表都市时髦态度;如有侵权、违规,可直接反应本站,咱们将会作删去处理。
下一篇:境外特务将黑手伸向职场结交软件 特务经过职场结交软件撮合策反我要点范畴人才